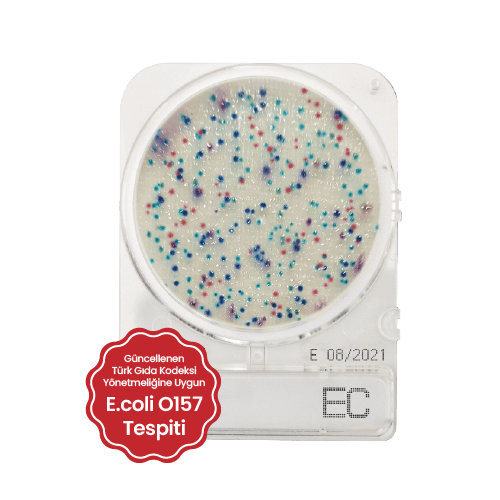

Yiyecek ve içeceklerdeki E.coli ve koliform bakterilerini tespit etmek için kullanılan hazır kromojenik bir plakadır. Koliform bakterilerin varlığı dışkı kontaminasyonunun ve su, deniz ürünleri, süt ürünleri ve diğer gıdalarda enterik patojenlerin olası varlığının bir göstergesidir. E. coli ve koliformların izlenmesi ve tanımlanması, gıda üretim sürecinin her aşamasında bir kalite kontrol parametresi olarak kullanılır.
Kromojenik besiyeri üzerinde, E. coli mavi veya turkuaz koloniler oluştururken, koliformlar bordo koloniler oluşturur. Besiyeri üzerindeki bordo ve mavi kolonilerin tamamı, toplam koliform sayısını verir.
E.coli 0157 formu Compact Dry EC besiyerinde pembe/magenta renginde üreme göstermektedir.

YORUMLAMA
E.coli mavi koloniler oluşturur. Bordo ve mavi koloniler birlikte toplam koliform grup sayısını oluşturur.
GENEL BİLGİ
E.Coli 0157 pembe/kırmızı/mor koloniler oluşturur.
Büyüme alanı 20 cm²'dir. Plakanın arkası, koloni sayımını kolaylaştırmak için 1 cm²'lik bir ızgaraya sahiptir. Çok sayıda koloni varsa, toplam koloni sayısı, birkaç ızgaradaki ortalama koloni sayısının 20 ile çarpılmasıyla elde edilebilir.
Yüksek konsantrasyonlar (>250 CFU) tüm büyüme alanının kromojenik üreme rengine dönüşmesine neden olur. Bu durumda, numuneyi seyreltin. Kullandıktan sonra lütfen yerel imha yönetmeliklerine uyun.
DEPOLAMA ve RAF ÖMRÜ
Oda sıcaklığında (+1 ila +30 °C) saklayın. Raf ömrü üretimden sonra 24 ay.
UYGULAMA
1. Kapağı açın.
2. 1 mL örneği besiyerinin ortasına inoküle edin.
3. Numune, besiyerine kendiliğinden eşit ve hızlı bir şekilde yayılır, kuru besiyerini saniyeler içerisinde jel haline getirir.
4. Besiyerinin kapağını kapatın, numune bilgilerini yazın.
5. Besiyerini ters çevirin (kapak aşağı doğru) ve uygun süre ve sıcaklıkta inkübe edin.
6. İnkübasyonun ardından kolonileri sayın.

